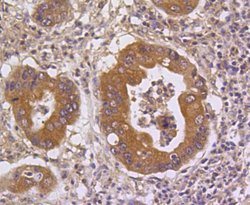
Invitrogen MKP3 Recombinant Rabbit Monoclonal Antibody (SR39-09) 100 &mu;L;

Learn More
Invitrogen™ MKP3 Recombinant Rabbit Monoclonal Antibody (SR39-09)


Rabbit Recombinant Monoclonal Antibody
Brand: Invitrogen™ MA531988
Description
Recombinant rabbit monoclonal antibodies are produced using in vitro expression systems. The expression systems are developed by cloning in the specific antibody DNA sequences from immunoreactive rabbits. Then, individual clones are screened to select the best candidates for production. The advantages of using recombinant rabbit monoclonal antibodies include: better specificity and sensitivity, lot-to-lot consistency, animal origin-free formulations, and broader immunoreactivity to diverse targets due to larger rabbit immune repertoire.
DUSP6 is a member of the dual specificity protein phosphatase subfamily. These phosphatases inactivate their target kinases by dephosphorylating both the phosphoserine/threonine and phosphotyrosine residues. They negatively regulate members of the mitogen-activated protein (MAP)kinase superfamily (MAPK/ERK, SAPK/JNK, p38), which are associatedwith cellular proliferation and differentiation. Different members of the family of dual specificity phosphatases show distinct substrate specificities for various MAP kinases, different tissue distribution and subcellular localization, and different modes of inducibility of their expression by extracellular stimuli. This gene product inactivates ERK2, is expressed in a variety of tissues with the highest levels in heart and pancreas, and unlike most other members of this family, is localized in the cytoplasm. Twotranscript variants encoding different isoforms have been found for the DUSP6 gene.
Specifications
| MKP3 | |
| Recombinant Monoclonal | |
| 1 mg/mL | |
| TBS with 0.05% BSA, 40% Glycerol and 0.05% sodium azide; pH 7.4 | |
| Q16828, Q64346, Q9DBB1 | |
| DUSP6 | |
| Recombinant protein within Human DUSP6 aa 325-381. | |
| 100 μL | |
| Primary | |
| Human, Mouse, Rat | |
| Antibody | |
| IgG |
| Immunohistochemistry (Paraffin), Western Blot, Immunocytochemistry, Western Blot, Western Blot | |
| SR39-09 | |
| Unconjugated | |
| DUSP6 | |
| 1300019I03Rik; dual specificity phosphatase 6; dual specificity protein phosphatase 6; Dual specificity protein phosphatase PYST1; Dusp6; DUSP6-ALT; HH19; MAP kinase phosphatase 3; mitogen-activated protein kinase phosphatase 3; Mkp3; MKP-3; PYST1; serine/threonine specific protein phosphatase | |
| Rabbit | |
| Protein A | |
| RUO | |
| 116663, 1848, 67603 | |
| Store at 4°C short term. For long term storage, store at -20°C, avoiding freeze/thaw cycles. | |
| Liquid |
Your input is important to us. Please complete this form to provide feedback related to the content on this product.